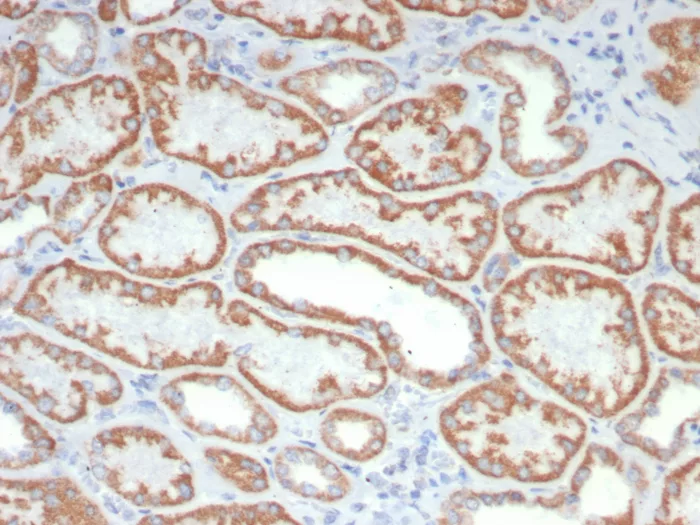
IHC analysis of formalin-fixed, paraffin-embedded human kidney stained using FGF23/6408 at 2ug/ml in PBS for 30min RT. HIER: Tris/EDTA, pH9.0, 45min. 2°C: HRP-polymer, 30min. DAB, 5min. FGF23 (Fibroblast Growth Factor 23) Antibody

IHC analysis of formalin-fixed, paraffin-embedded human kidney stained using FGF23/6408 at 2ug/ml in PBS for 30min RT. HIER: Tris/EDTA, pH9.0, 45min. 2°C: HRP-polymer, 30min. DAB, 5min.

SDS-PAGE Analysis of Purified FGF23 Mouse Monoclonal Antibody (FGF23/6408). Confirmation of Purity and Integrity of Antibody.

Analysis of Protein Array containing more than 19,000 full-length human proteins using FGF23 Mouse Monoclonal Antibody (FGF23/6408). Z- and S- Score: The Z-score represents the strength of a signal that a monoclonal antibody (MAb) (in combination with a fluorescently-tagged anti-IgG secondary antibody) produces when binding to a particular protein on the HuProtTM array. Z-scores are described in units of standard deviations (SD's) above the mean value of all signals generated on that array. If targets on HuProtTM are arranged in descending order of the Z-score, the S-score is the difference (also in units of SD's) between the Z-score. S-score therefore represents the relative target specificity of a MAb to its intended target. A MAb is considered to specific to its intended target, if the MAb has an S-score of at least 2.5. For example, if a MAb binds to protein X with a Z-score of 43 and to protein Y with a Z-score of 14, then the S-score for the binding of that MAb to protein X is equal to 29.
Fibroblast growth factor-1 (FGF-1), also designated acidic FGF, and fibroblast growth factor-2 (FGF-2), also designated basic FGF, are members of a family of growth factors that stimulate proliferation of cells of mesenchymal, epithelial and neuroectodermal origin. Additional members of the FGF family include the oncogenes FGF-3 (Int2) and FGF-4 (hst/Kaposi), FGF-5, FGF-6, FGF-7 (KGF), FGF-8 (AIGF), FGF-9 (GAF) and FGF-10 through FGF-23. Members of the FGF family share 30-55% amino acid sequence identity and similar gene structure, and are capable of transforming cultured cells when overexpressed in transfected cells. Cellular receptors for FGFs are members of a second multigene family, including four tyrosine kinases designated Flg (FGFR-1), Bek (FGFR-L), TKF and FGFR-3.
There are no reviews yet.